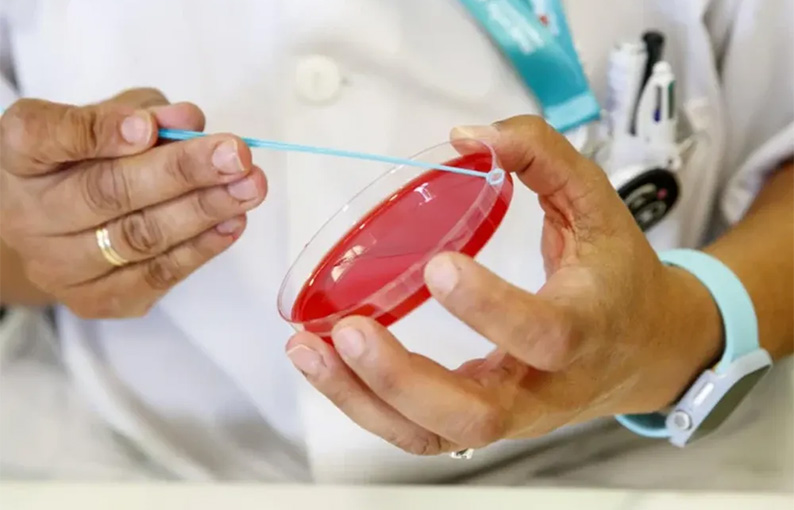

Es el número más alto de casos de sífilis registrado hasta el momento. La cartera de Salud de la Nación ratificó que es una tendencia que crece desde hace 15 años, a excepción de los dos años de pandemia.
De acuerdo al último Boletín Epidemiológico Nacional del Ministerio de Salud, en 2025 se registraron 46.799 casos de sífilis, confirmando un aumento sostenido que se viene registrando en el país desde hace 15 años. Esa cifra es la más alta registrada.
Con una tasa de independencia de 117,2 casos por cada 100 mil habitantes, “la evolución del número absoluto de casos notificados permite observar, desde 2011, una tendencia creciente en la notificación que se acelera a partir de 2015”, señala el Boletín Epidemiológico.
Si bien, durante 2020 y 2021 se verifica una disminución en la cantidad de notificaciones a causa del impacto de la pandemia en el sistema de salud, a partir de 2022 se retoma la tendencia ascendente con una mayor aceleración. En 2023 se superaron los 30.000 casos anuales por primera vez desde el inicio de la serie, y en 2025 se alcanzó el valor más alto registrado hasta el momento.
La sífilis a nivel mundial
El comportamiento de la sífilis a nivel nacional se enmarca dentro de un escenario de aumento acelerado en todo el mundo y en la Región de las Américas. En 2022, alrededor de 8 millones de adultos de 15 a 49 años adquirieron la infección en el mundo. Se estima que solo en la Región de las Américas se produjeron 3,36 millones de nuevas infecciones en ese mismo año y que alrededor de 3,4 millones de personas viven con la enfermedad. Esto representa un aumento cercano al 30% con respecto a 2020, aun considerando las interrupciones generadas por la pandemia.
Los números en la Argentina
Dentro de nuestro país, las tasas de incidencia regionales mantienen comportamientos similares desde el año 2021. Las regiones Sur y Cuyo se posicionan por encima del promedio nacional. En 2025, la región Sur presentó la mayor incidencia en su población (159,8 casos cada 100 mil habitantes), seguida por Cuyo en donde la tasa fue de 137,5 casos cada 100 mil habitantes.
En las regiones del NOA y NEA se observa una tendencia de aumento con oscilaciones interanuales. En 2025, la tasa de incidencia del NEA fue de 133 casos por cada 100 mil habitantes, y la de la región del NOA, de 111,7 casos por cada 100 mil habitantes. Finalmente, la región Centro se mantuvo por debajo del promedio nacional, con una tasa de 109,4 casos por cada 100 mil habitantes.
La sífilis por edades
Siguiendo la misma tendencia observada a nivel mundial, en nuestro país la sífilis afecta mayoritariamente en jóvenes y adultos jóvenes. Mientras que el grupo de 15 a 39 años concentró el 76% del total de casos del país (35.497 registros) en 2025, la población de entre 20 a 24 años presentó la tasa de incidencia más alta, con 290,6 casos cada 100 mil habitantes. En este rango, la afectación en mujeres (366 casos cada 100 mil habitantes) es significativamente mayor que en varones (tasa de 218,2). A partir de los 50 años se observa una inversión del perfil por sexo. Las tasas comienzan a ser superiores en los varones, duplicando la tasa femenina en el grupo de 65 a 69 años.
Qué hace el Ministerio de Salud
Ante este escenario, la cartera sanitaria nacional implementa un abordaje integral que incluye vigilancia, diagnóstico, tratamiento y articulación estratégica. En 2025, se creó la Mesa Ministerial de ITS, un espacio de gestión que reúne a referentes de prevención, diagnóstico, tratamiento y vigilancia. Actualmente, está trabajando en un Plan Operativo Anual para garantizar una respuesta homogénea en todas las jurisdicciones del país a través de estrategias de prevención combinada, testeos en puntos de atención, acceso oportuno al tratamiento, fortalecimiento de la vigilancia epidemiológica y el uso de la información para la toma de decisiones sanitarias.











